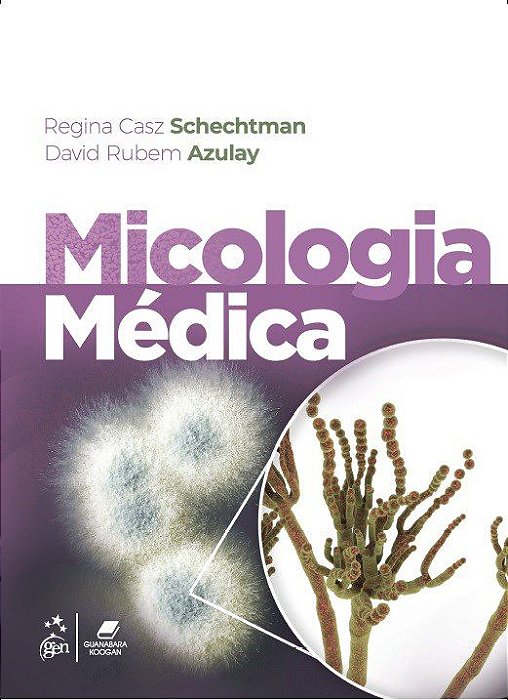
Livro Micologia Médica Azulay

Livro Micologia Médica Azulay
-
- 1x de R$ 409,00 sem juros
- 2x de R$ 204,50 sem juros
- 3x de R$ 136,33 sem juros
- 4x de R$ 102,25 sem juros
- 5x de R$ 81,80 sem juros
- 6x de R$ 68,16 sem juros
- 7x de R$ 58,42 sem juros
- 8x de R$ 51,12 sem juros
- 9x de R$ 45,44 sem juros
- 10x de R$ 40,90 sem juros
- 11x de R$ 37,18 sem juros
- 12x de R$ 34,08 sem juros
-
- 1x de R$ 409,00 sem juros
- 2x de R$ 224,21
- 3x de R$ 151,64
- 4x de R$ 113,87
- 5x de R$ 93,51
- 6x de R$ 77,93
- 7x de R$ 68,20
- 8x de R$ 59,68
- 9x de R$ 54,39
- 10x de R$ 49,35
- 11x de R$ 44,86
- 12x de R$ 41,62
-
R$ 388,55

ISBN 9788527738071
Edição 1
Ano 2022
Idioma Português
Autor Schechtman/azulay
Páginas 296
Encadernação Brochura
Coordenado pela Professora Regina Casz Schechtman, especialista e apaixonada pelo assunto, com a participação do Professor David Rubem Azulay, que, como dermatologista eminentemente clínico, reconhece, em muito, a importância da micologia na prática médica.Micologia Médica foi organizado em 28 capítulos, que abordam relevantes temas, entre os quais, métodos atuais de diagnóstico, como PCR, testes sorológicos, meios de cultura, e os modernos antifúngicos tão fundamentais para as novas condições clínicas advindas da quantidade cada vez maior de pacientes imunossuprimidos e de exposições decorrentes de viagens a locais exóticos. Além disso, trata da importante questão das interações medicamentosas com os novos fármacos introduzidos na medicina, bem como do crescente desenvolvimento de resistência fúngica a vários antifúngicos antes eficientes.
Sumário:
1 Noções Básicas de Micologia
2 Diagnóstico Laboratorial das Micoses
3 Tinea Nigra
4 Piedra Negra
5 Piedra Branca
6 Pitiríase Versicolor
7 Dermatofitoses
8 Candidíases
9 Infecções Superficiais por Fungos Filamentosos não Dermatófitos
10 Feoifomicoses Subcutâneas
11 Cromoblastomicose
12 Esporotricose
13 Micetomas
14 Lobomicose
15 Rinosporidiose
16 Entomoftoromicoses
17 Criptococose
18 Paracoccidioidomicos
19 Histoplasmose
20 Coccidioidomicose
21 Mucormicoses
22 Talaromicose (Antiga Peniciliose)
23 Prototecose e Pitiose (“Fungos Falsos”)
24 Antifúngicos
25 Micoses Oportunistas por Leveduras
26 Micoses Oportunistas por Fungos Filamentosos
27 Micoses de Importação
28 Histopatologia das Micoses
Índice Alfabético
Sobre o Autor:
Regina Casz Schechtman
Professora Associada e Coordenadora do Curso de Pós-Graduação em Dermatologia da Pontifícia Universidade Católica do Rio de Janeiro (PUC-Rio). Chefe do Setor de Micologia do Instituto de Dermatologia Professor Rubem David Azulay (IDPRDA) da Santa Casa da Misericórdia do Rio de Janeiro. Doutora em Dermatologia pela University of London (St. John’s Institute of Dermatology, St. Thomas & Guy’s Hospitals). Médica Graduada pela Universidade do Estado do Rio de Janeiro (UERJ). Pós-Graduada no Serviço de Dermatologia do Hospital Universitário Pedro Ernesto (HUPE/UERJ).
David Rubem Azulay
Professor Titular do Curso de Pós-Graduação em Dermatologia da Pontifícia Universidade Católica do Rio de Janeiro (PUC-Rio). Chefe de Serviço do Instituto de Dermatologia Professor Rubem David Azulay (IDPRDA) da Santa Casa da Misericórdia do Rio de Janeiro. Professor Adjunto de Dermatologia da Universidade Federal do Rio de Janeiro (UFRJ) e da Fundação Técnico-Educacional Souza Marques.
Mestre e Doutor em Dermatologia pela UFRJ. Pós-Graduado no Serviço de Dermatologia (Professor Raul Fleischmajer) do Mount Sinai Hospital, EUA, e no Serviço de Dermatologia (Professor Jean Civatte) do Hospital Saint Louis, França.
Produtos relacionados
-
 Livro Compêndio de Micologia Médica: Zaitz GuanabaraR$ 749,00até 12x de R$ 62,41 sem jurosou R$ 711,55 via Boleto Bancário
Livro Compêndio de Micologia Médica: Zaitz GuanabaraR$ 749,00até 12x de R$ 62,41 sem jurosou R$ 711,55 via Boleto Bancário -
 Livro Dermatologia Azulay 2025R$ 1.243,00até 12x de R$ 103,58 sem jurosou R$ 1.180,85 via Boleto Bancário
Livro Dermatologia Azulay 2025R$ 1.243,00até 12x de R$ 103,58 sem jurosou R$ 1.180,85 via Boleto Bancário -
 Livro Dermatologia: Azulay GuanabaraR$ 1.306,00até 12x de R$ 108,83 sem jurosou R$ 1.240,70 via Boleto Bancário
Livro Dermatologia: Azulay GuanabaraR$ 1.306,00até 12x de R$ 108,83 sem jurosou R$ 1.240,70 via Boleto Bancário -
 Livro Azulay Atlas de Dermatologia da Semiologia ao DiagnósticoR$ 1.498,00até 12x de R$ 124,83 sem jurosou R$ 1.423,10 via Boleto Bancário
Livro Azulay Atlas de Dermatologia da Semiologia ao DiagnósticoR$ 1.498,00até 12x de R$ 124,83 sem jurosou R$ 1.423,10 via Boleto Bancário
-
A Livro Pro é uma livraria especializada em livros técnicos e didáticos, com atuação focada nas áreas da saúde, direito, ciências humanas e ciências exatas. Nosso catálogo é cuidadosamente selecionado para atender às necessidades de estudantes, professores, pesquisadores e profissionais, oferecendo obras atualizadas, reconhecidas academicamente e alinhadas às exigências do mercado e da formação educacional. Trabalhamos com conteúdos que apoiam a graduação e pós-graduação até a atualização profissional!